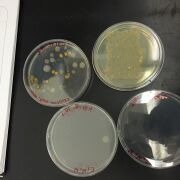

Uploads by Christian Ortiz
From OpenWetWare
Jump to navigationJump to search
This special page shows all uploaded files.
| Date | Name | Thumbnail | Size | Description |
|---|---|---|---|---|
| 21:52, 22 March 2015 | Screen Shot 2015-03-22 at 5.35.10 PM.png (file) | 20 KB | ||
| 21:52, 22 March 2015 | Screen Shot 2015-03-22 at 5.35.08 PM.png (file) |  |
175 KB | |
| 21:51, 22 March 2015 | Screen Shot 2015-03-22 at 5.35.03 PM.png (file) |  |
139 KB | |
| 21:50, 22 March 2015 | Screen Shot 2015-03-22 at 5.35.01 PM.png (file) |  |
84 KB | |
| 21:49, 22 March 2015 | Screen Shot 2015-03-22 at 5.34.59 PM.png (file) |  |
93 KB | |
| 21:49, 22 March 2015 | Screen Shot 2015-03-22 at 5.34.57 PM.png (file) |  |
92 KB | |
| 00:45, 18 February 2015 | IMG 1970 copy.jpg (file) |  |
130 KB | |
| 23:14, 15 February 2015 | Screen Shot 2015-02-15 at 6.13.57 PM.png (file) |  |
125 KB | |
| 22:15, 15 February 2015 | IMG 1788 copy.jpeg (file) |  |
62 KB | |
| 22:13, 15 February 2015 | IMG 1791 copy.jpg (file) |  |
116 KB | |
| 22:13, 15 February 2015 | IMG 1795 copy.jpg (file) |  |
76 KB | |
| 22:07, 15 February 2015 | Invertab.png (file) |  |
85 KB | |
| 15:16, 11 February 2015 | IMG 1703 copy.jpg (file) |  |
389 KB | |
| 15:06, 11 February 2015 | IMG 1418 copy.jpg (file) |  |
66 KB | |
| 15:05, 11 February 2015 | IMG 1380 copy.jpg (file) |  |
114 KB | |
| 15:05, 11 February 2015 | IMG 1339 copy.jpg (file) |  |
95 KB | |
| 14:51, 11 February 2015 | IMG 1278 copy.jpg (file) |  |
123 KB | |
| 14:47, 11 February 2015 | IMG 1285 copy.jpg (file) |  |
146 KB | |
| 14:46, 11 February 2015 | IMG 1291 copy.jpg (file) |  |
88 KB | |
| 14:43, 11 February 2015 | IMG 1290 copy.jpg (file) |  |
144 KB | |
| 14:41, 11 February 2015 | IMG 1282 copy.jpg (file) |  |
195 KB | |
| 14:40, 11 February 2015 | IMG 1288 copy.jpg (file) |  |
123 KB | |
| 14:34, 11 February 2015 | IMG 1283 copy.jpg (file) |  |
188 KB | |
| 14:33, 11 February 2015 | IMG 1287 copy.jpg (file) |  |
120 KB | |
| 14:29, 11 February 2015 | IMG 1284 copy.jpg (file) |  |
178 KB | |
| 14:29, 11 February 2015 | IMG 1286 copy.jpg (file) |  |
58 KB | |
| 14:20, 11 February 2015 | Screen Shot 2015-02-11 at 9.14.27 AM.png (file) |  |
77 KB | |
| 03:06, 4 February 2015 | IMG 0994.jpg (file) |  |
1.26 MB | |
| 03:05, 4 February 2015 | IMG 1271.jpg (file) |  |
1.48 MB | |
| 02:54, 4 February 2015 | Screen Shot 2015-02-03 at 9.52.23 PM.png (file) |  |
48 KB | |
| 02:18, 4 February 2015 | IMG 0709 copy.jpg (file) |  |
158 KB | |
| 02:17, 4 February 2015 | IMG 0770 copy.jpg (file) |  |
126 KB | |
| 02:07, 4 February 2015 | Screen Shot 2015-02-03 at 9.07.04 PM.png (file) |  |
49 KB | |
| 02:05, 4 February 2015 | Screen Shot 2015-02-03 at 9.03.25 PM.png (file) |  |
39 KB | |
| 01:51, 4 February 2015 | IMG 0702.jpg (file) |  |
159 KB | |
| 01:28, 4 February 2015 | IMG 0766copy.jpg (file) |  |
132 KB | |
| 01:28, 4 February 2015 | IMG 0762 copy.jpg (file) |  |
137 KB | |
| 01:28, 4 February 2015 | IMG 0754 copy.jpg (file) |  |
174 KB | |
| 01:28, 4 February 2015 | IMG 0748 copy.jpg (file) |  |
134 KB | |
| 01:27, 4 February 2015 | IMG 0743 copy.jpg (file) |  |
128 KB | |
| 01:27, 4 February 2015 | IMG 0736 copy.jpg (file) |  |
136 KB | |
| 01:27, 4 February 2015 | IMG 0729 copy.jpg (file) |  |
126 KB | |
| 01:27, 4 February 2015 | IMG 0723 copy.jpg (file) | |
124 KB | |
| 01:26, 4 February 2015 | IMG 0706 copy.jpg (file) |  |
223 KB | |
| 01:26, 4 February 2015 | IMG 0705 copy.jpg (file) |  |
161 KB | |
| 01:26, 4 February 2015 | IMG 0704 copy.jpg (file) |  |
165 KB | |
| 01:25, 4 February 2015 | IMG 0703 copy.jpg (file) |  |
114 KB | |
| 01:25, 4 February 2015 | IMG 0702 copy.jpg (file) |  |
159 KB | |
| 16:28, 28 January 2015 | Microscope.jpeg (file) |  |
19 KB | |
| 16:28, 28 January 2015 | IMG 0700 copy.jpg (file) |  |
26 KB |